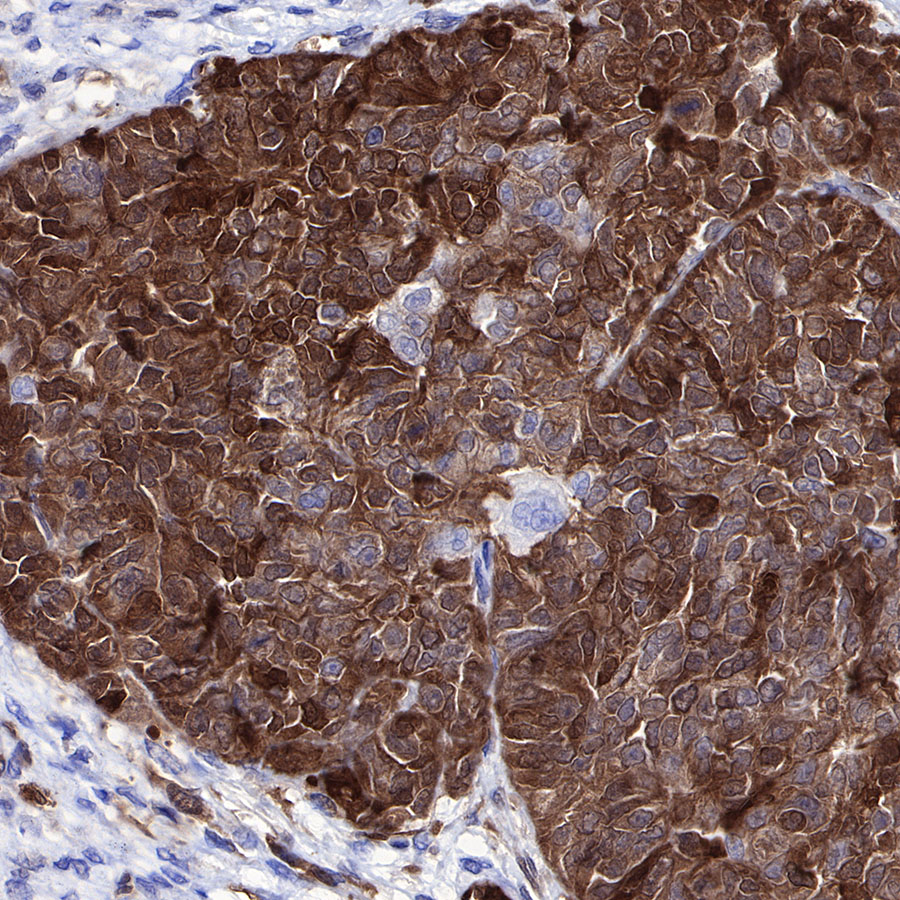

WB result of Stathmin 1Rabbit mAb
Primary antibody: Stathmin 1 Rabbit mAb at 1/1000 dilution
Lane 1: MCF7 whole cell lysate 20 µg
Lane 2: HeLa whole cell lysate 20 µg
Secondary antibody: Goat Anti-Rabbit IgG, (H+L), HRP conjugated at 1/10000 dilution
Predicted MW: 17kDa
Observed MW: 17kDa
Product Details
Product Details
Product Specification
| Host | Rabbit |
| Antigen | Stathmin 1 |
| Synonyms | Stathmin, Leukemia-associated phosphoprotein p18, Metablastin, Op18, pp19, Prosolin, Protein Pr22, pp17, C1orf215, LAP18 |
| Immunogen | Synthetic Peptide |
| Location | Cytoplasm, Cytoskeleton |
| Accession | P16949 |
| Clone Number | SDT-383-4 |
| Antibody Type | Recombinant mAb |
| Application | WB, IHC-P, ICC, ICFCM |
| Reactivity | Hu, Ms, Rt |
| Purification | Protein A |
| Concentration | 0.5 mg/ml |
| Conjugation | Unconjugated |
| Physical Appearance | Liquid |
| Storage Buffer | PBS, 40% Glycerol, 0.05% BSA, 0.03% Proclin 300 |
| Stability & Storage | 12 months from date of receipt / reconstitution, -20 °C as supplied |
Dilution
| application | dilution | species |
| WB | 1:1000 | |
| IHC-P | 1:2000 | |
| ICC | 1:2000 | |
| ICFCM | 1:500 |
Background
Stathmin 1 (STMN1), also known as p17, p18, p19, 19K, metablastin, oncoprotein 18, LAP 18 and Op18, is a 19 kDa cytosolic protein. It was the first discovered member of a family of phylogenetically related microtubule-destabilizing phosphoproteins critically involved in the construction and function of the mitotic spindle. A threshold level of STMN1 is required for orderly progression through mitosis in a variety of cell types. STMN1 is overexpressed across a broad range of human malignancies (leukemia, lymphoma, neuroblastoma; ovarian, prostatic, breast and lung cancers and mesothelioma). It is also upregulated in normally proliferating cell lines but is only rarely upregulated in nonproliferating cell lines with the exception of neurons, anterior pituitary cells and glial cells [PMID: 18759697].
Picture
Picture
Western Blot


WB result of Stathmin 1 Rabbit mAb
Primary antibody: Stathmin 1 Rabbit mAb at 1/1000 dilution
Lane 1: NIH/3T3 whole cell lysate 20 µg
Lane 2: mouse brain lysate 20 µg
Secondary antibody: Goat Anti-Rabbit IgG, (H+L), HRP conjugated at 1/10000 dilution
Predicted MW: 17kDa
Observed MW: 17kDa

WB result of Stathmin 1 Rabbit mAb
Primary antibody: Stathmin 1 Rabbit mAb at 1/1000 dilution
Lane 1: C6 whole cell lysate 20 µg
Lane 2: rat brain lysate 20 µg
Secondary antibody: Goat Anti-Rabbit IgG, (H+L), HRP conjugated at 1/10000 dilution
Predicted MW: 17kDa
Observed MW: 17kDa
FC

Flow cytometric analysis of 4% PFA fixed 90% methanol permeabilized C2C12 (Mouse myoblasts myoblast) labelling Stathmin 1 antibody at 1/500 dilution (0.1 μg) / (Red) compared with a Rabbit monoclonal IgG (Black) isotype control and an unlabelled control (cells without incubation with primary antibody and secondary antibody) (Blue). Goat Anti - Rabbit IgG Alexa Fluor® 488 was used as the secondary antibody.
Immunohistochemistry

IHC shows positive staining in paraffin-embedded human cerebral cortex. Anti-Stathmin 1 antibody was used at 1/2000 dilution, followed by a HRP Polymer for Mouse & Rabbit IgG (ready to use). Counterstained with hematoxylin. Heat mediated antigen retrieval with Tris/EDTA buffer pH9.0 was performed before commencing with IHC staining protocol.

IHC shows positive staining in paraffin-embedded human liver. Anti-Stathmin 1 antibody was used at 1/2000 dilution, followed by a HRP Polymer for Mouse & Rabbit IgG (ready to use). Counterstained with hematoxylin. Heat mediated antigen retrieval with Tris/EDTA buffer pH9.0 was performed before commencing with IHC staining protocol.

IHC shows positive staining in paraffin-embedded human spleen. Anti-Stathmin 1 antibody was used at 1/2000 dilution, followed by a HRP Polymer for Mouse & Rabbit IgG (ready to use). Counterstained with hematoxylin. Heat mediated antigen retrieval with Tris/EDTA buffer pH9.0 was performed before commencing with IHC staining protocol.

IHC shows positive staining in paraffin-embedded human tonsil. Anti-Stathmin 1 antibody was used at 1/2000 dilution, followed by a HRP Polymer for Mouse & Rabbit IgG (ready to use). Counterstained with hematoxylin. Heat mediated antigen retrieval with Tris/EDTA buffer pH9.0 was performed before commencing with IHC staining protocol.

IHC shows positive staining in paraffin-embedded human breast cancer. Anti-Stathmin 1 antibody was used at 1/2000 dilution, followed by a HRP Polymer for Mouse & Rabbit IgG (ready to use). Counterstained with hematoxylin. Heat mediated antigen retrieval with Tris/EDTA buffer pH9.0 was performed before commencing with IHC staining protocol.

IHC shows positive staining in paraffin-embedded human lung squamous cell carcinoma. Anti-Stathmin 1 antibody was used at 1/2000 dilution, followed by a HRP Polymer for Mouse & Rabbit IgG (ready to use). Counterstained with hematoxylin. Heat mediated antigen retrieval with Tris/EDTA buffer pH9.0 was performed before commencing with IHC staining protocol.
IHC shows positive staining in paraffin-embedded human ovarian carcinoma. Anti-Stathmin 1 antibody was used at 1/2000 dilution, followed by a HRP Polymer for Mouse & Rabbit IgG (ready to use). Counterstained with hematoxylin. Heat mediated antigen retrieval with Tris/EDTA buffer pH9.0 was performed before commencing with IHC staining protocol.

IHC shows positive staining in paraffin-embedded mouse cerebral cortex. Anti-Stathmin 1 antibody was used at 1/2000 dilution, followed by a HRP Polymer for Mouse & Rabbit IgG (ready to use). Counterstained with hematoxylin. Heat mediated antigen retrieval with Tris/EDTA buffer pH9.0 was performed before commencing with IHC staining protocol.

IHC shows positive staining in paraffin-embedded rat cerebral cortex. Anti-Stathmin 1 antibody was used at 1/2000 dilution, followed by a HRP Polymer for Mouse & Rabbit IgG (ready to use). Counterstained with hematoxylin. Heat mediated antigen retrieval with Tris/EDTA buffer pH9.0 was performed before commencing with IHC staining protocol.

IHC shows positive staining in paraffin-embedded rat testis. Anti-Stathmin 1 antibody was used at 1/2000 dilution, followed by a HRP Polymer for Mouse & Rabbit IgG (ready to use). Counterstained with hematoxylin. Heat mediated antigen retrieval with Tris/EDTA buffer pH9.0 was performed before commencing with IHC staining protocol.
Immunocytochemistry

ICC shows positive staining in C2C12 cells. Anti-Stathmin 1 antibody was used at 1/2000 dilution (Green) and incubated overnight at 4°C. Goat polyclonal Antibody to Rabbit IgG - H&L (Alexa Fluor® 488) was used as secondary antibody at 1/1000 dilution. The cells were fixed with 4% PFA and permeabilized with 0.1% PBS-Triton X-100. Nuclei were counterstained with DAPI (Blue).






























